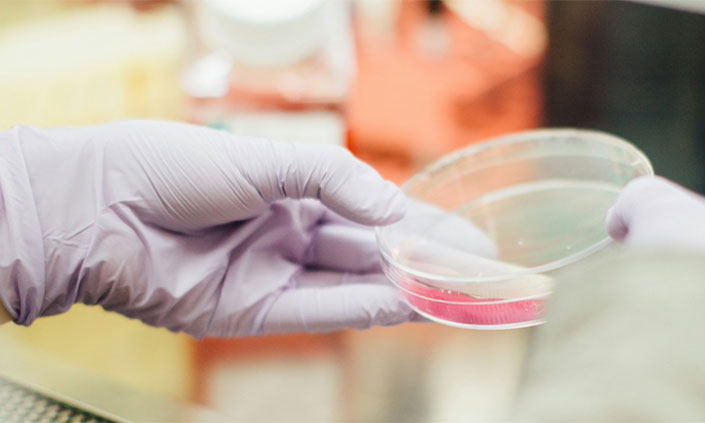

How oral cancer evades immune system: New research
A new study has uncovered pathways used by oral cancer to evade the immune system, potentially opening doors for improved treatments.
Balaclava Rd, North Ryde, Macquarie University
NSW 2109 Australia
Macquarie University researchers have discovered new information about how oral cancer cells may block the body’s immune response. This could lead to better treatments for this aggressive disease.
Their reaserch, published in the Journal of Oral biosciences this month
Their research, published in the Journal of Oral Biosciences this month, looked at protein interactions in oral cancer cells that might stop our immune cells from attacking these tumours.
Oral cancer is the sixth most common cancer in Australia and the most common in India. Advanced forms of oral cancer are hard to treat, with patients typically surviving less than 12 months.
Lead author Dr Rajdeep Chakraborty from Applied Biosciences at Macquarie University says the study offers important clues about how oral cancer avoids the immune system.
“We thought there might be proteins in oral cancer cells working together to reduce immune cell attack,” Dr Chakraborty says.
Dr Chakraborty is principal investigator of the project, and is also a dentoalveolar surgeon and a Macquarie University PhD graduate.
Resistant to treatment
Oral cancer includes cancers of the lips, tongue, cheeks, mouth, palate, sinuses, and throat. Risk factors include tobacco use, heavy alcohol use, and HPV infection.
Early detection greatly improves survival rates for oral cancer. However, advanced disease remains very difficult to treat effectively.
Immunotherapy, which aims to boost the body’s natural defences against cancer, has shown promise in some cancers but has had limited success in oral cancer. This new research may help explain why and point to new approaches.
The research focused on a protein called ‘signal transducer and activator of transcription 3’ – shortened to STAT3, which helps oral cancer cells grow. The team used advanced proteomic techniques to see which other proteins STAT3 interacts with in oral cancer cells.
“Our findings suggest that STAT3 and its protein partners are possibly acting as a confounder, and camouflaging cancer cells from being targeted during anti-cancer treatment in oral cancer.”
3D Cancer model
Dr Chakraborty developed a new three-dimensional cancer model for this research, which is now patented.
“The three-dimensional cancer model I developed puts cancer cells together with the immune cells rather than using mouse models that often don’t translate to human research.
“Human oral tissue cells are taken and prepared in such a way that the immune cells interact with oral cancer cells simultaneously to mimic tumour behaviour.”
Researchers then used mass spectrometry on the 3D models to identify the proteins interacting with STAT3.
The researchers found that STAT3 was much higher in all oral cancer cell types studied compared to normal oral cells.
They also found a protein called epidermal growth factor receptor (EGFR) was closely linked to STAT3 in oral cancer cells, and several other proteins that interacted with STAT3 were involved in controlling the immune system, including some known to suppress it.
Their analysis showed STAT3 and its partner proteins may be involved in pathways that help cancer avoid the immune system.
New treatment options
Dr Chakraborty says the research opens new possibilities for oral cancer treatment, particularly addressing drug resistance.
The team is now exploring combinations of treatments, such as combining STAT3 monoclonal or engineered antibodies with EGFR treatment.
“Initial phase one and phase two reports have shown this to be working,” Dr Chakraborty says.
“This study reveals potential new drug targets that could help boost the immune response against oral cancer cells,” he says.
The findings may also explain why some oral cancers become resistant to existing immunotherapy treatments.
Associate Professor Fei Liu, from the School of Natural Sciences at Macquarie University, is a chemist interested in precision therapeutics targeting cancer mechanisms and a collaborator on the research.
She says the team used a range of techniques in this study, including 3D cell culture, proteomics, and bioinformatics analysis.
“This multi-pronged approach allowed researchers to examine potentially unanticipated protein interactions in a model that may better mimic the environment of real tumours,” says Associate Professor Liu.
Dr Chakraborty says more research is needed to confirm the results and develop potential therapies.
“This is an important first step, but we now need to confirm these protein interactions and see if targeting them can boost anti-tumour immune responses,” he says.
Drug resistance
“Our preliminary data could shed light on why aggressive oral cancers often become resistant to cetuximab, one of the main FDA-approved targeted therapies,” Dr Chakraborty says.
(Cetuximab is a monoclonal antibody that targets EGFR, one of the key proteins identified in this study as interacting with STAT3).
“We hope this research will lead to new drug development and provide hope for oral cancer patients - particularly those with aggressive oral cancers that currently have very poor prognosis,” Dr Chakraborty says.
The research was funded by a 2021 grant from the Australian and New Zealand Head and Neck Cancer Society (ANZHNCS), and Dr Chakraborty was awarded the Trudi Shine Adenoid Cystic Carcinoma Grant to pursue this work.